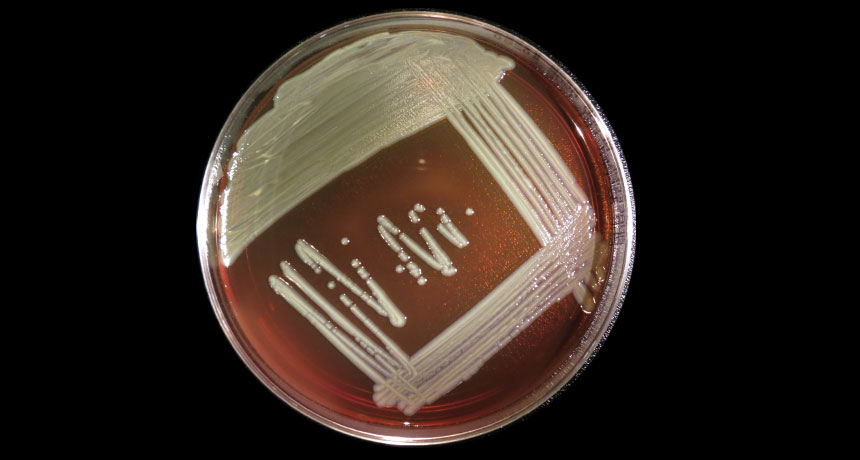
Elizabethkingia bacteria

Benign-turned-deadly bacterium baffles scientists
As patient count rises, source of Elizabethkingia infections remains mysterious
STILL NO ANSWER The source of infection with Elizabethkingia bacteria (shown here growing on a blood agar plate) in Wisconsin and two other states remains unknown.
Photo courtesy of the CDC Special Bacteriology Reference Lab